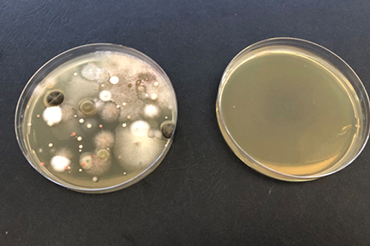
Testy účinnosti ozónového generátora

Dezinfikátor EVOMED SOA25A využijete takmer všade. Ľahko prenosné a nabíjateľné zariadenie sa s...
Blog, Strana 2
Výpis článkov
Štúdia účinnosti sterilizácie vzduchu generátormi ozónu vyrobenými spoločnosťou EVONA ELECTRONIC, sp...
Dezinfikátor EVOMED SOA25A využijete takmer všade. Ľahko prenosné a nabíjateľné zariadenie sa s...
Baktérie sú mikroskopické organizmy, ktoré sú súčasťou každodenného života. Niektoré baktérie ...
Čistota a hygiena sú dôležitým elementom kvalitných kozmetických, pedikérskych, kaderníckych alebo m...
V každom kvalitnom ubytovacom zariadení je hygiena a bezpečnosť klienta na prvom mieste. Hotely sa r...
Premýšľate nad dezinfekciou, ktorá je bezpečná, no zároveň účinná? Dezinfekcia ozónom sa aktívne vyu...
Sila ozónu likviduje baktérie, vírusy, plesne a výnimkou nie sú ani alergény. Alergén je väčšin...
Súčasné prepuknutie epidémie vyvolalo rastúci záujem o inovatívnu dezinfekčnú technológiu. Práve v d...
Ozón je účinným eliminátorom dymu, pachov a baktérií. V krátkom čase zničí až 99,99 % všetkých škodl...